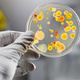
Bacteria 2

-
Varias epidemias de causa desconocida afectan a la población.
-
Girolamo Fracastoro postuló que unos seres diminutos eran los causantes de la enfermedad, pero no logró demostrarlo.
Plan projects on a visual timeline
Map milestones, phases, deadlines, and key events in one place so the sequence is easier to see and share. Timetoast is a timeline maker for work, school, research, and stories.